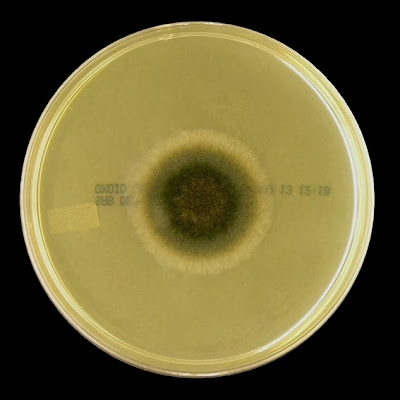
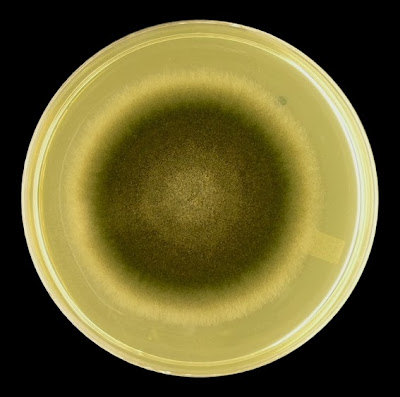

Exserohilum rostratum (Mould)
Ecology:
Exserohilumspecies are dematiaceous fungi (ie black mould), widely distributed in nature. They are cosmopolitan, commonly found on many plants and grasses and can also be isolated from soils and water.
Pathogenicity:
Exserohilum species are unlikely human pathogens. Exserohilum species have been implicated in phaeohyphomycosis[i]. Most commonly they are isolated from nasal sinuses (sinusitis) and the eye (keratitis) after a scratch or traumatic injury.
In 2012, Exserohilum rostratum was implicated as the primary pathogen isolated from injectable methylprednisolone. Numerous patients receiving steroid therapy primarily for degenerative lumbar-disk and joint disease in the U.S., developed meningitis after injection. While normally not invasive, the fungus will cause illness when directly injected into the body. While sources vary in statistics, injectable methylprednisolone contaminated with Exserohilum rostratum appears to have been responsible for sickening upwards of 700 people, 30 of which died. Many others continue to have ongoing neurological problems associated the infection or subsequent therapy.
Macroscopic Morphology:
E.rostratumexhibits rapid growth and matures within 4 to 5 days.
Surface growth is grey in colour, quickly darkening with the production of melanin, eventually developing shades from olive to brown to black.
The texture is woolly or cottony in appearance.
Exserohilum rotratum SAB 30oC, 72 Hours
Exserohilum rostratum SAB 30oC, 1 Week
Microscopic Morphology:
Hyphae are septate and darken with the development of melanin. Conidiophores are rather long (up to 200 - 230 µm in length, 5 – 8 µm wide) and are also septate. Conidiophores exhibit sympodial geniculate growth, where conidia are produced at bends (geniculate) as the conidiophore extends. This gives the conidiophore a knobby, zigzag appearance where the conidia attach. The mature conidia (ave. 14 X 80 µm or greater) are straight to slightly curved and are fusiform or ellipsoidal in shape with rather smooth walls. Conidia are compartmentalized with between 7 to 11 septa and has a distinctive protruding dark hilum (scar) at the base where once attached.More specifically, the conidia are ‘poroconidia’, a distinction where the conidia are produced through the extrusion or extension of the inner walls of the conidiogenous cells through a pore or channel.
Exserohilum rostratum -First look. Free conidia. Tape mount at 250X (LPCB, DMD-108)
Exserohilum rostratum -Conidia attached to septate hyphae (400X, LPCB, Nikon)
Exserohilum rostratum - Large, compartmentalized conida which are somewhat fusiform in appearance and may appear slightly bent or curved. (400X, LPCB, DMD-108)
Exserohilum rostratum - as above. Showing variation in size and shape of conidia. Brown pigmentation due to the production and accumulation of melanin. (400X, LPCB, DMD-108)
Exserohilum rostratum - Conidia attached to conidiophore.
(400X, LPCB, DMD-108)
Exserohilum rostratum - as above, conidia attached to conidophore seen extending through the camera's plane of focus. (400X, LPCB, DMD-108)
Exserohilum rostratum - a closer look at the septate conidiophore and the attachment of the conidia to the conidiophore. Note the bent or zig-zag location on the conidiophore at the point of conidial attachment. This appearance us referred to as geniculate growth. (400X, LPCB, Nikon)
Exserohilum rostratum - Pigmented, fusiform shaped conidia, usually containing between7 to 11 internal septa. Note the prominent projection or hilum (arrow) which remains at the point of the attachment to the conidiophore. (400+10X, LPCB, DMD-108)
Exserohilum roatratum - single conidium with hilum visble on right side. Length reads 76.01
µm. (400+10X, LPCB, DMD-108)
µm. (400+10X, LPCB, DMD-108)
Exserohilum rostratum - another view of the geniculate growth / attachment of the conidia to the conidiophore. (400X, LPCB, DMD-108)
Exserohilum rostratum - Single conidium attached to conidiophore.
(1000X, LPCB, DMD-108)
Exserohilum rostratum - okay, I like photos! Another loose conidium which is slightly bent. This one has seven, possibly eight compartments. The conidium is smooth walled and again, the hilum is clearly visible at one end. (1000X, LPCB, DMD-108)
Exserohilum rostratum - More photos, just for the beauty of this organism.
(1000X, LPCB, DMD-108)
Exserohilum rostratum
Exserohilum rostatum - geniculate (zig-zag) conidiophore after the conidia have dispersed.
(400X, LPCB, DMD-108)
Caution:
Exserohilum species may be confused with Bipolaris and Drechslera species however Exserohilum has the protuberant hilum.
[i] A particular presentation of a fungal infection in tissue caused by certain dematiaceous fungi. This presentation may be an initial clue as to the particular fungus responsible for the infection. 'Google' the term for a better definition.
* * *
.jpg)
.jpg)

.jpg)




.jpg)







